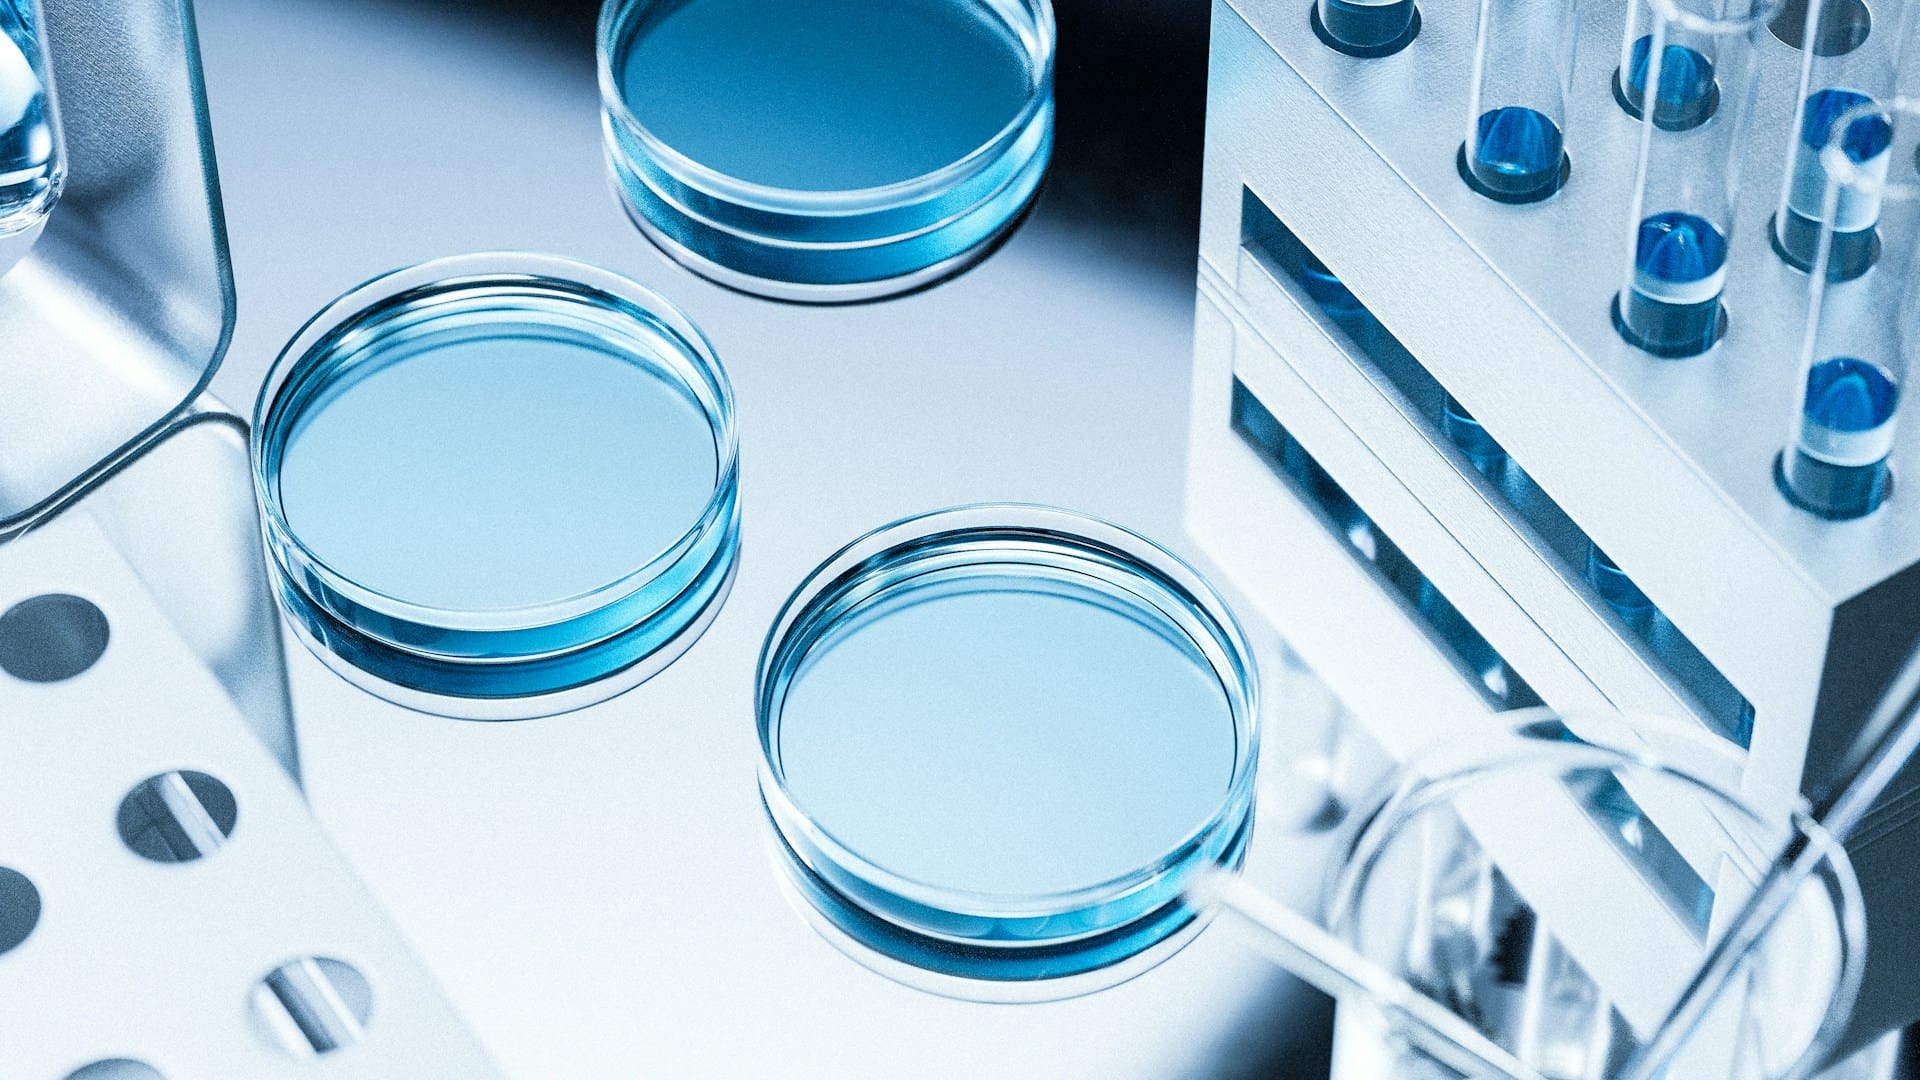

You share your goals, audience, and requirements
We dig into the subject matter and gather what’s needed
We write. You review
Final content, ready to publish

Alastair Grigg
Founder of (Re)in Asia
Colette Steckel
Asia Pacific edition, MESA edition (South Asia content)
Accounting and Business magazine
ACCA